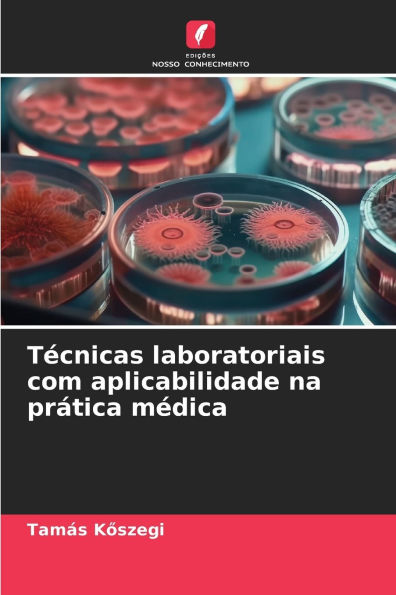
TÃ¯Â¿Â½cnicas laboratoriais com aplicabilidade na prÃ¯Â¿Â½tica mÃ¯Â¿Â½dica

Home
Telehealth Unbound: Pr�tica cl�nica e cuidados aos doentes a n�vel mundial
Barnes and Noble
Loading Inventory...
Telehealth Unbound: Pr�tica cl�nica e cuidados aos doentes a n�vel mundial in Franklin, TN
Current price: $51.00

Barnes and Noble
Telehealth Unbound: Pr�tica cl�nica e cuidados aos doentes a n�vel mundial in Franklin, TN
Current price: $51.00
Loading Inventory...
Size: OS
A telemedicina já não é uma visão distante - é uma realidade emergente que está a transformar os cuidados de saúde. Este livro traça essa viagem desde as primeiras consultas remotas até ao mundo de ponta dos cuidados virtuais imersivos. Exploramos a forma como as tecnologias fundamentais (telefone, rádio, televisão em circuito fechado) abriram caminho para as actuais redes de vídeo de elevada largura de banda e para as inovações em matéria de IA, realidade virtual/aumentada (RV/RA), telepresença e cadeia de blocos. Abordamos também os desafios éticos, jurídicos e práticos em cada fase. Com base em exemplos históricos, investigação moderna e projectos-piloto emergentes, esta narrativa oferece aos profissionais de saúde, aos decisores políticos e aos tecnólogos uma visão abrangente e equilibrada. O objetivo é apresentar a história da telemedicina num tom envolvente e autoritário - destacando os sucessos, reconhecendo os desafios e inspirando um planeamento informado para a próxima geração de cuidados ligados.
A telemedicina já não é uma visão distante - é uma realidade emergente que está a transformar os cuidados de saúde. Este livro traça essa viagem desde as primeiras consultas remotas até ao mundo de ponta dos cuidados virtuais imersivos. Exploramos a forma como as tecnologias fundamentais (telefone, rádio, televisão em circuito fechado) abriram caminho para as actuais redes de vídeo de elevada largura de banda e para as inovações em matéria de IA, realidade virtual/aumentada (RV/RA), telepresença e cadeia de blocos. Abordamos também os desafios éticos, jurídicos e práticos em cada fase. Com base em exemplos históricos, investigação moderna e projectos-piloto emergentes, esta narrativa oferece aos profissionais de saúde, aos decisores políticos e aos tecnólogos uma visão abrangente e equilibrada. O objetivo é apresentar a história da telemedicina num tom envolvente e autoritário - destacando os sucessos, reconhecendo os desafios e inspirando um planeamento informado para a próxima geração de cuidados ligados.